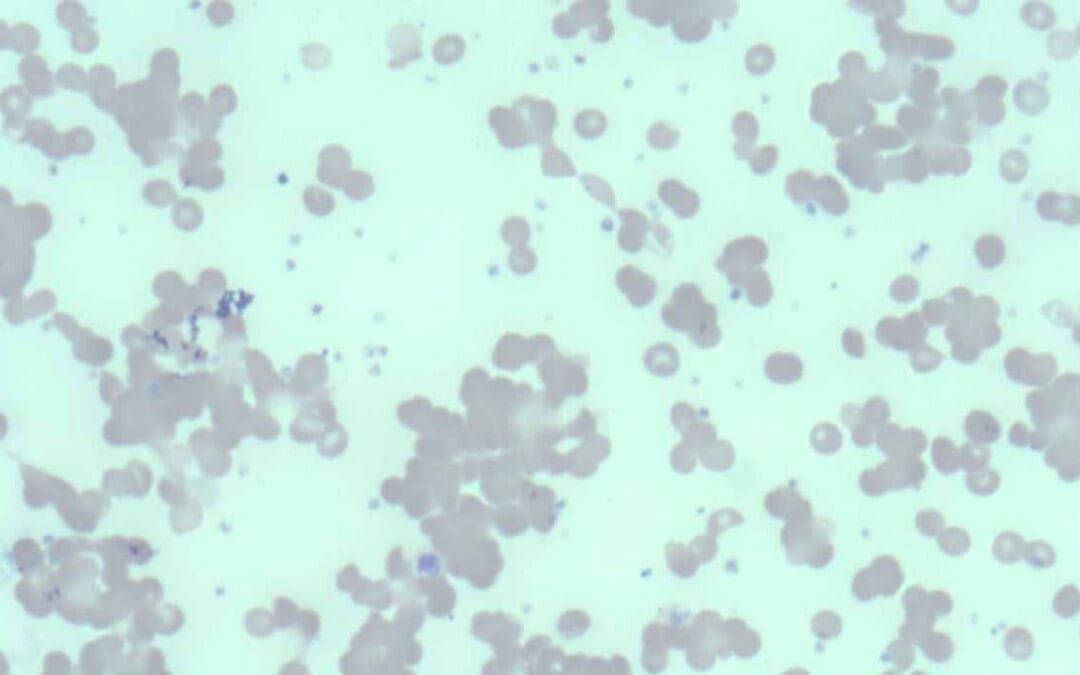

Erythropoietin (EPO) is a hormone that stimulates red blood cell production. It plays a crucial role in oxygen transport and is used to treat anemia in various conditions like kidney disease and cancer.
Fanconi Anemia
Fanconi anemia, a rare genetic disorder, causes bone marrow failure and increases cancer risk. Learn about symptoms, causes, diagnosis, and treatment options.
Neonatal Jaundice (High Bilirubin Levels in Newborns)
Neonatal jaundice is a common condition in newborns causing yellowing of the skin and eyes due to excess bilirubin in the blood. It can be caused by various factors, including immature liver function and certain medical conditions. While often harmless, severe cases can lead to complications.

Warm Autoimmune Hemolytic Anemia (warm AIHA)
Warm AIHA: Immune system attacks red blood cells, causing anemia. Symptoms include fatigue, pallor, and jaundice. Treatment targets immune suppression.
Cold Agglutinin Disease
Cold Agglutinin Disease (CAD) is a rare autoimmune anemia. Cold-reactive antibodies destroy red blood cells, causing fatigue, cold sensitivity, and anemia.

Hemolytic Uremic Syndrome (HUS)
Hemolytic uremic syndrome (HUS): A rare but serious condition causing red blood cell damage, low platelets, and kidney failure. Early diagnosis is key.
Conventional PCR Protocol for Downstream Sequencing in Beta Thalassemia Diagnosis
The beta globin gene PCR protocol for sequencing involves amplifying the beta globin gene using specific primers, followed by Sanger sequencing to determine the DNA sequence.
Aplastic Anemia (AA): A Bone Marrow Failure
Aplastic Anemia, a rare and serious bone marrow failure syndrome, causes pancytopenia, where all the blood cell lineages are suppressed.
Erythrocyte sedimentation rate (ESR)
ESR measures the sedimentation rate or the length red blood cells fall in a vertical tube over a period of time.
Brilliant Cresyl Blue (BCB) Stain (Methylene Blue)
BCB or new methylene blue (NMB) stains are also known as supravital stains. These stains are commonly used to stain reticulocytes, Heinz bodies or H inclusions
Preparation of Peripheral Blood Smears
A drop of blood spread on a slide, reveals morphological abnormalities of the blood cells that can be viewed under the microscope.
CBC with Differential and Other Reference Ranges
Reference ranges like complete blood count (CBC) with differential are important because they provide a baseline for interpreting laboratory test results.